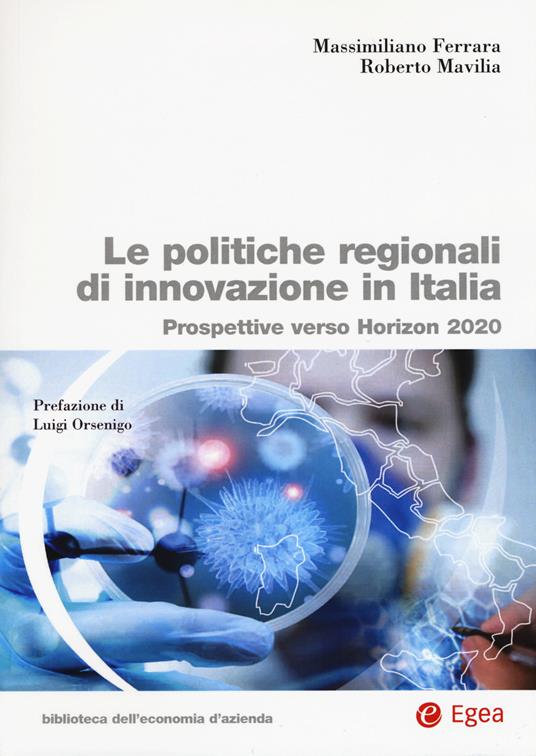
Le politiche regionali innovazione in Italia. Prospettive verso Horizon 2020 - Massimiliano Ferrara,Roberto Mavilia - copertina

Le politiche regionali innovazione in Italia. Prospettive verso Horizon 2020
Prezzo minimo ultimi 30 giorni: 40,80 €
Le politiche per l'innovazione sono da individuarsi oggi come elemento nodale per lo sviluppo socio-economico di un Paese. Non è infatti possibile concepire l'idea di progresso di un territorio in maniera disgiunta dalla sua capacità di produrre, elaborare e sfruttare le risultanze dell'attività di ricerca nei diversi ambiti di applicazione. Particolare rilevanza assume nel contesto italiano l'apporto delle regioni, enti territoriali ai quali è demandato l'onere di incentivare la nascita e il consolidamento di un framework per l'implementazione di politiche per l'innovazione che riverberino effetti positivi non circoscritti in via esclusiva all'ambito regionale ma in grado di impattare positivamente sullo sviluppo dell'intero Paese. Il volume si propone di indagare in maniera analitica lo stato dell'arte delle politiche regionali per l'innovazione e i loro risvolti: con un approccio evolutivo, si mira ad individuare il momento, il metodo e le ragioni che rendono possibile per le regioni il passaggio ad avanzati paradigmi e a innovative traiettorie di apprendimento, così da trarre, tra gli altri, il vantaggio della mitigazione del rischio di incappare in inefficienze strutturali dovute alla persistenza. Prendendo le mosse dalle linee di indirizzo comunitarie e nazionali, si giunge infine a fornire una lettura critica delle politiche oggetto d'analisi, anche attraverso opportune comparazioni tra le strategie attuate nelle diverse aree geografiche nazionali, senza tralasciare il confronto con altri Paesi...
-
Autore:
-
Editore:
-
Collana:
-
Anno edizione:2015
-
In commercio dal:24 novembre 2015
Le schede prodotto sono aggiornate in conformità al Regolamento UE 988/2023. Laddove ci fossero taluni dati non disponibili per ragioni indipendenti da Feltrinelli, vi informiamo che stiamo compiendo ogni ragionevole sforzo per inserirli. Vi invitiamo a controllare periodicamente il sito www.lafeltrinelli.it per eventuali novità e aggiornamenti.
Per le vendite di prodotti da terze parti, ciascun venditore si assume la piena e diretta responsabilità per la commercializzazione del prodotto e per la sua conformità al Regolamento UE 988/2023, nonché alle normative nazionali ed europee vigenti.
Per informazioni sulla sicurezza dei prodotti, contattare productsafety@feltrinelli.it